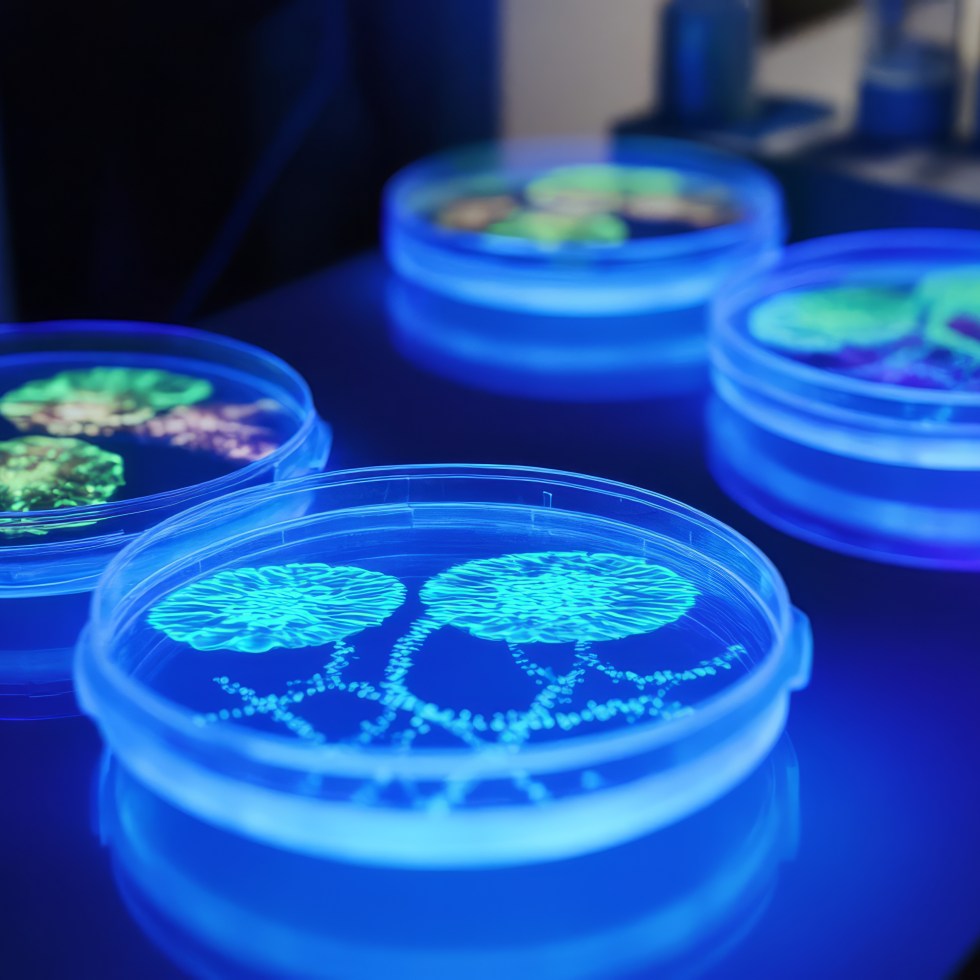

Category: Green Chemistry

“Biohacking in Textiles : Unlocking Sustainable Innovation While Navigating Environmental and Ethical Trade-offs”

Harnessing Nature-Based Solutions for Corporate Sustainability in the Textile Chemical Industry

The Intersection of Green and Just Transition in the Fashion Industry

The Sustainability Struggle: Why the Fashion Industry Hesitates to Embrace Change

Embracing Cradle to Cradle, Cradle to Grave, and Cradle to Gate in Textile Wet Processing”
